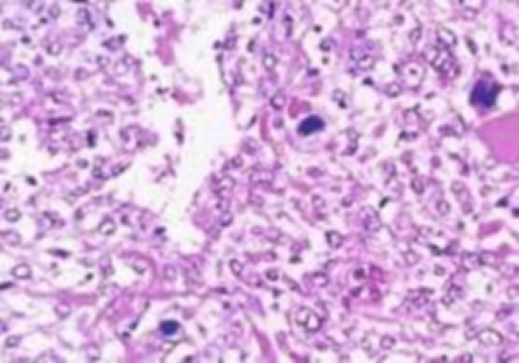

寄生虫是一类生活在其他生物体内并从中获取营养的微生物。虽然人们在日常生活中可能很少意识到它们的存在,但人体寄生虫感染在某些地区和特定条件下仍然是一个常见的健康问题。尤其在一些环境卫生条件较差和生活方式不健康的地区,寄生虫感染的风险较高。及早发现和治疗寄生虫感染对于保护个人健康和防止传播扩散至关重要。在临床实践中,医生通常会借助多种检查项目来诊断人体是否感染了寄生虫,以确保准确有效的治疗。寄生虫感染的常见检查项目有哪些呢?
1.血液检验。血液检验是检测寄生虫感染的一种常见方法。通过分析患者的血液样本,医生可以寻找寄生虫引起的抗体、寄生虫的存在或相关的病理指标。不同的寄生虫可能会引发不同的免疫反应,因此血液检验可以帮助确定感染的类型和严重程度。例如,疟疾、血吸虫病等都可以通过血液来检测。

2.粪便检查。粪便检查是检测肠道寄生虫感染的重要手段。在某些情况下,寄生虫的卵或幼虫可以在患者的粪便中被检测到。这种检查适用于多种寄生虫感染,如蛔虫、钩虫、弓形虫等。医生在实验室中进行显微镜检查,以便确定是否存在寄生虫卵或其他相关标志物。

3.影像学检查。影像学检查如X射线、CT扫描和超声波可以帮助医生观察身体内部的异常情况,特别是寄生虫引起的组织损伤。例如,囊虫病在肝脏中形成囊泡,可以通过超声波来检测。这些检查方法对于寄生虫感染导致人体内部器官损伤的诊断和监测非常有用。

4.分子生物学检查。分子生物学技术在寄生虫感染的诊断中扮演着越来越重要的角色。通过检测寄生虫的DNA或RNA序列,医生可以准确地确定寄生虫的存在和种类。这种方法尤其适用于感染量较少或难以通过其他方法检测的情况。

5.组织检查。在某些情况下,医生可能需要进行组织检查,以确定寄生虫是否侵入了特定的组织或器官。这通常通过活检来实现,其中医生从患者体内取得一小块组织样本,然后在实验室进行固定、染色、切片、显微镜下观察等组织检查步骤。
总之,寄生虫感染的检查项目多种多样,采取哪些检查方法主要取决于感染的类型和严重程度。对于怀疑自己可能感染寄生虫的人来说,最好的做法是尽快就医,请专业医生根据症状和检查结果进行准确的诊断和治疗。日常生活中我们要重视预防寄生虫感染,保持良好的个人卫生习惯和饮食习惯可以减少感染寄生虫的风险。